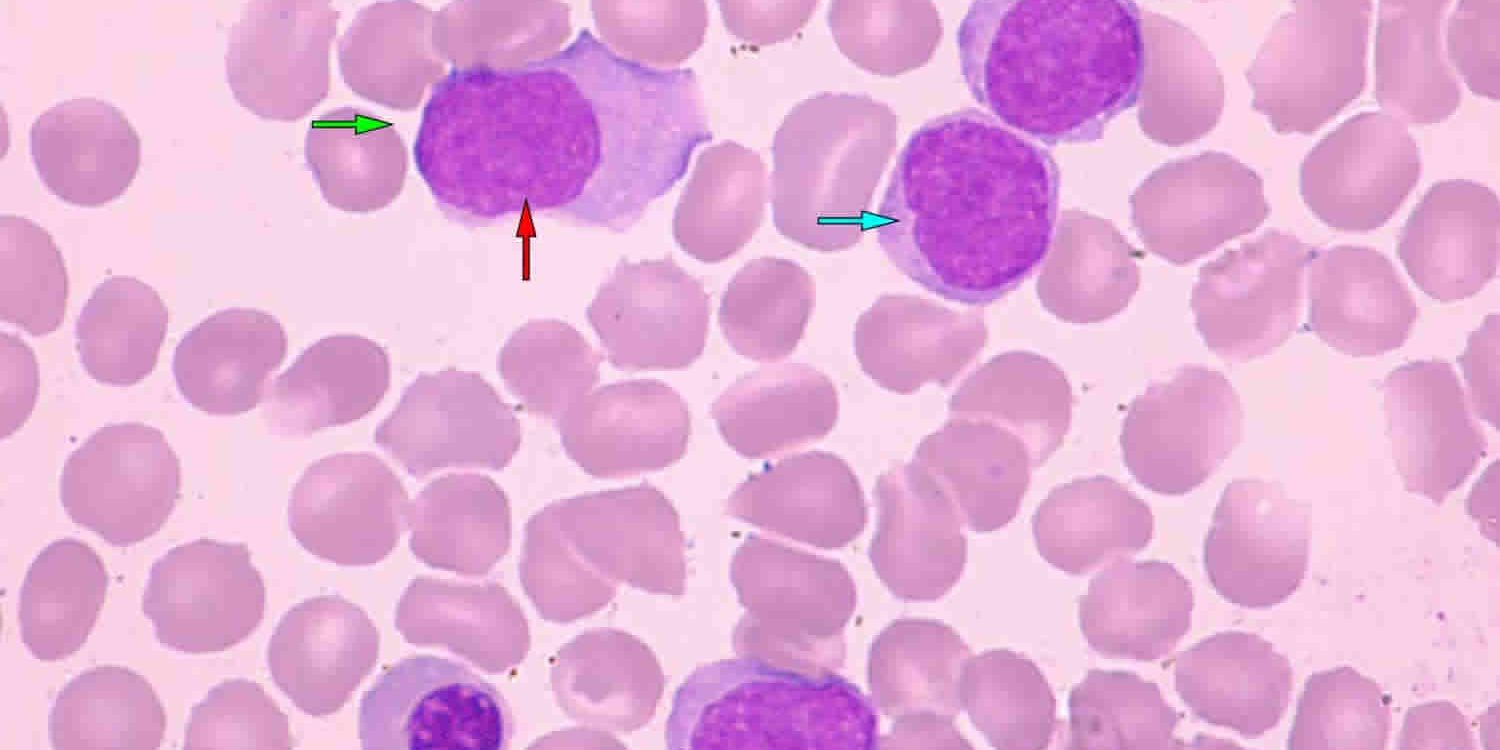

Panel for diagnosis Mantle cell lymphoma
CD45, CD5, CD19, CD10, CD20, CD23, CD200, FMC7, Lambda, Kappa
لنفومای سلول منتل یکی از انواع لنفومای غیرهوچکین است که بیشتر سلولهای B را درگیر میکند و اغلب با پیشرفت سریع مشخص میشود. این بیماری معمولاً در بزرگسالان میانسال و مسن دیده میشود و میتواند با علائمی مانند تورم غدد لنفاوی، خستگی، کاهش وزن و عفونتهای مکرر همراه باشد. تشخیص دقیق این بیماری از طریق بیوپسی و استفاده از آزمایشات پیشرفته مانند فلوسایتومتری انجام میگیرد. فلوسایتومتری به پزشکان امکان میدهد تا خصوصیات سلولهای موجود در نمونه را بر اساس ویژگیهای فیزیکی و شیمیایی آنها تجزیه و تحلیل کنند.
در پنل تشخیصی لنفومای سلول منتل، چندین مارکر مخصوص مورد استفاده قرار میگیرند که عبارتند از:
-
CD45: یک مارکر پایه برای شناسایی سلولهای خونی سفید، که در تشخیص لنفومای سلول منتل مهم است.
-
CD5: این مارکر در برخی از سلولهای B و همچنین سلولهای T بیان میشود. حضور آن در لنفومای سلول منتل کمک کننده است.
-
CD19 و CD20: هر دوی این مارکرها مختص سلولهای B هستند و در تشخیص لنفومای سلول منتل کاربرد دارند.
-
CD10: این مارکر در برخی از انواع لنفوم، از جمله لنفومای سلول منتل، بیان میشود.
-
CD23 و CD200: این دو مارکر میتوانند در تفکیک لنفومای سلول منتل از دیگر انواع لنفومها مفید باشند.
-
FMC7: این مارکر خاص در تشخیص لنفومای سلول منتل نقش دارد و میتواند به تفکیک آن از سایر انواع لنفوم کمک کند.
-
Lambda و Kappa: این دو مارکر مربوط به زنجیرههای سبک ایمونوگلوبولین هستند و در تعیین کلونالیته سلولها در لنفومای سلول منتل کاربرد دارند.
استفاده از این پنل مارکرها در فلوسایتومتری به پزشکان امکان میدهد تا با دقت بیشتری لنفومای سلول منتل را تشخیص دهند و در نتیجه به طراحی راهبرد درمانی موثرتر برای بیماران کمک کنند. شناخت دقیق وجود و نوع مارکرها میتواند نقش مهمی در تعیین پروگنوز بیماری و انتخاب درمان مناسب داشته باشد. این روش تشخیصی پیشرفته به درک بهتر از بیماری و امکانات درمانی موجود کمک شایانی میکند و به پزشکان اجازه میدهد تا با دقت بیشتری به بررسی وضعیت بیماری و پاسخ به درمان بپردازند.